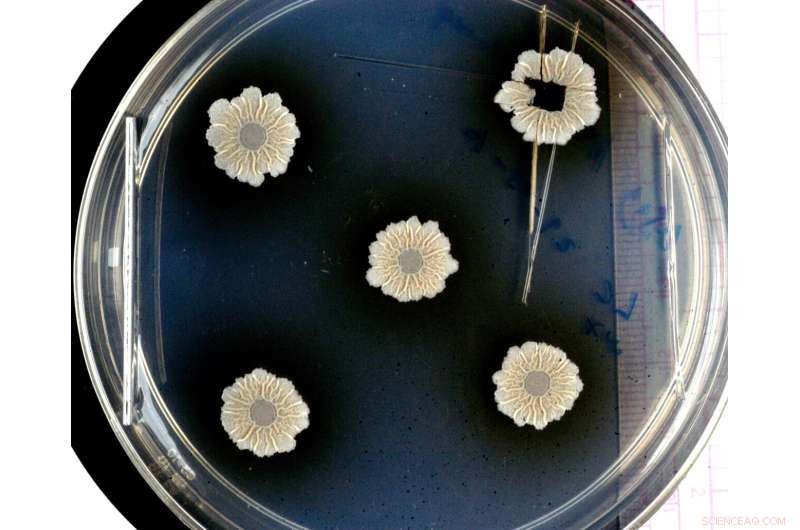
Biofilms: Understanding Microbial Communities and Their Impact

When bacteria join together to form communities, they may build complex structures. The photo shows wild-type Bacillus subtilis biofilms. Credit: Liraz Chai/HUJI
Most bacteria have the ability to form communities, biofilms, that adhere to a wide variety of surfaces and are difficult to remove. This can lead to major problems, for example in hospitals or in the food industry. Now, an international team led by Hebrew University, Jerusalem, and the Technical University Dresden, has studied a model system for biofilms at the synchrotron radiation facilities BESSY II at HZB and the ESRF and found out what role the structures within the biofilm play in the distribution of nutrients and water.
Bacterial biofilms can thrive on almost all types of surfaces: We find them on rocks and plants, on teeth and mucous membranes, but also on contact lenses, medical implants or catheters, in the hoses of the dairy industry or drinking water pipes, where they can pose a serious threat to human health. Some biofilms are also useful, for example, in the production of cheese, where specific types of biofilms not only produce the many tiny holes, but also provide its delicious taste.
Tissue with special structures
"Biofilms are not just a collection of very many bacteria, but a tissue with special structures," explains Prof. Liraz Chai from the Hebrew University in Jerusalem. Together, the bacteria form a protective layer of carbohydrates and proteins, the so-called extracellular matrix. This matrix protects the bacteria from disinfectants, UV radiation or desiccation and ensures that biofilms are really difficult to remove mechanically or eradicate chemically. However, the matrix is not a homogeneous sludge: "It's a bit like in a leaf of plants, there are specialized structures, for example water channels residing in tiny wrinkles," says Chai. But what role these structures play and what happens at the molecular level in a biofilm was not known until now. Together with Prof. Yael Politi, TU Dresden, an expert in the characterization of biological materials, Chai therefore applied for measurement time at the synchrotron radiation source BESSY II at HZB.
"The good thing about BESSY II is that we can map quite large areas. By combining X-ray diffraction with fluorescence, not only can we analyze the molecular structures across the biofilm very precisely, but we can also simultaneously track the accumulation of certain metal ions that are transported in the biofilm and learn about some of their biological roles" Yael Politi points out.
Model system for many biofilms
As samples, the scientists used biofilms from Bacillus subtilis, a harmless bacterium that thrives on plant roots and forms a useful symbiosis with them: it stores water so that the plant can possibly take moisture from the biofilm during drought and they also protect the roots from pathogens. In return, the cells in the biofilm feeds on root exudates. Nevertheless, Bacillus subtilis bacteria can serve as a model system for many other bacterial biofilms.
At the MySpot beamline of BESSY II, they examined a large area (mm2) from these biofilm samples. They were able to spatially resolve the structures within the biofilm and distinguish well between matrix components, bacterial cells, spores and water. " X-ray fluorescence spectroscopy, is a method that allows us to identify important metal-ions such as calcium, zinc, manganese and iron," even when present in trace amounts, says Dr. Ivo Zizak, HZB physicist in charge of the MySpot beamline. This made it possible to correlate between biofilm morphology and metal ion distribution.
Spore formation at unexpected locations
The evaluation shows that calcium ions preferentially accumulate in the matrix, while zinc, manganese and iron ions accumulate along the wrinkles, where they can possibly trigger the formation of spores, which are important for the dispersion of the bacteria.
"We didn't expect that, because normally spores form under stress, e.g. dehydration. But here they are linked with water channels, probably due to the accumulation of metal ions," says Chai.
The results show that the structures in the matrix not only play an important role in the distribution of nutrients and water, but also actively influence the bacteria's ability to behave as a multicellular organism. "This could help us to better deal with biofilms overall, with the beneficial ones as well as the harmful ones," says Liraz Chai.